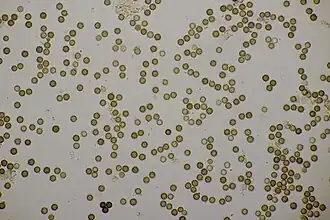
Výtrusy hvězdovky trojité

Hvězdovkotvaré
 Hvězdovka vakovitá | |
| Vědecká klasifikace | |
| Říše | houby (Fungi) |
| Oddělení | houby stopkovýtrusné (Basidiomycota) |
| Třída | stopkovýtrusné houby (Basidiomycetes) |
| Podtřída | rouškaté houby (Agaricomycetidae) |
| Řád | hvězdovkotvaré (Geastrales) Hosaka & Castellano 2007 |
| čeledi | |
| |
| Sesterská skupina | |
| Hadovkotvaré | |
| Některá data mohou pocházet z datové položky. | |
Hvězdovkotvaré (Geastrales) je název řádu stopkovýtrusných hub, který zahrnuje čtyři čeledi břichatek, tj. hub s uzavřenými plodnicemi vyplněnými výtrusorodým rouškem. Jde o saprotrofní houby s dvou- či vícevrstevným obalem (okrovkou) plodnice. Vnější vrstva většinou puká několika cípy, které se poté hvězdovitě otevírají, existují ale i zástupci s nepukavou, hlízovitou plodnicí[1] (nejčastěji jde o zástupce rodu hvězdovka, jejichž plodnice sekundárně ztratila schopnost se otevírat).[2] Výtrusorodá výplň plodnice (tedy teřich čili gleba) je za zralosti tmavá (okrově hnědá až černá) a má prachovitou konzistenci. Výtrusy jsou zpravidla kulovité nebo skoro kulovité a mají značně členitý reliéf. Do substrátu (humusem bohaté půdy, tlejícího dřeva apod.) často vrůstají silnými myceliálními svazky (rhizomorfami). Je u nich častá produkce krystalů šťavelanu vápenatého.[1]
Ekologicky jde o značně různorodou skupinu: jsou známy suchomilné pouštní druhy i druhy z deštných pralesů, druhy vázané na zásadité i kyselé substráty, druhy chladnomilné i tropické. Rod hvězdovka (Geastrum) je z rodů řazených do tohoto řádu zdaleka druhově nejbohatší – zahrnuje skoro 150 popsaných druhů, přičemž další jsou stále popisovány.[1] V České republice se lze setkat asi s 20 druhy hvězdovek, vzácně též s příbuznou mnohokrčkou (Myriostoma) a s droboučkým hrachovcem (Sphaerobolus).[3][4]
Do řádu jsou řazeny čtyři čeledi, a to hvězdovkovité (Geastraceae), Schenellaceae, hrachovcovité (Sphaerobolaceae) a Sclerogastraceae.[1][5] Řád byl v současném pojetí ustanoven v roce 2006 v publikaci vycházející z výsledků fylogenetických analýz a z porovnání morfologie těchto a dalších břichatkovitých hub, zejména pýchavek, s nimiž byly do té doby hvězdovkotvaré často spojovány.[6]
- Ukázky hvězdovkotvarých hub a jejich morfologie
-
 Mnohokrčka dírkovaná
Mnohokrčka dírkovaná -
 Hvězdovka Geastrum fuscogleba s nepukající plodnicí
Hvězdovka Geastrum fuscogleba s nepukající plodnicí -
 Hrachovec hvězdovitý
Hrachovec hvězdovitý -
Výtrusy hvězdovky trojité
Výtrusy hvězdovky trojité
Reference
- ↑ a b c d HE, Mao-Qiang; CAO, Bin; LIU, Fei. Phylogenomics, divergence times and notes of orders in Basidiomycota. Fungal Diversity. 2024-07-09, roč. 126, čís. 1, s. 127–406. Dostupné online [cit. 2025-02-19]. ISSN 1878-9129. doi:10.1007/s13225-024-00535-w. (anglicky)
- ↑ JEPPSON, Mikael; NILSSON, R. Henrik; LARSSON, Ellen. European earthstars in Geastraceae (Geastrales, Phallomycetidae) – a systematic approach using morphology and molecular sequence data. Systematics and Biodiversity. 2013-12, roč. 11, čís. 4, s. 437–465. Dostupné online [cit. 2025-02-22]. ISSN 1477-2000. doi:10.1080/14772000.2013.857367. (anglicky)
- ↑ Česká mykologická společnost. Geastrales. www.myko.cz [online]. [cit. 2025-02-22]. Dostupné online.
- ↑ HOLEC, Jan; BIELICH, Antonín; BERAN, Miroslav. Přehled hub střední Evropy. 2. vyd. Praha: [s.n.], 2024. ISBN 978-80-200-3586-8.
- ↑ HYDE, Kd. The 2024 Outline of Fungi and fungus-like taxa. Mycosphere. 2024, roč. 15, čís. 1, s. 5146–6239. Dostupné online [cit. 2025-02-22]. doi:10.5943/mycosphere/15/1/25.
- ↑ HOSAKA, Kentaro; BATES, Scott T.; BEEVER, Ross E. Molecular phylogenetics of the gomphoid-phalloid fungi with an establishment of the new subclass Phallomycetidae and two new orders. Mycologia. 2006-11, roč. 98, čís. 6, s. 949–959. Dostupné online [cit. 2025-02-22]. ISSN 0027-5514. doi:10.1080/15572536.2006.11832624. (anglicky)
Externí odkazy
 Obrázky, zvuky či videa k tématu hvězdovkotvaré na Wikimedia Commons
Obrázky, zvuky či videa k tématu hvězdovkotvaré na Wikimedia Commons